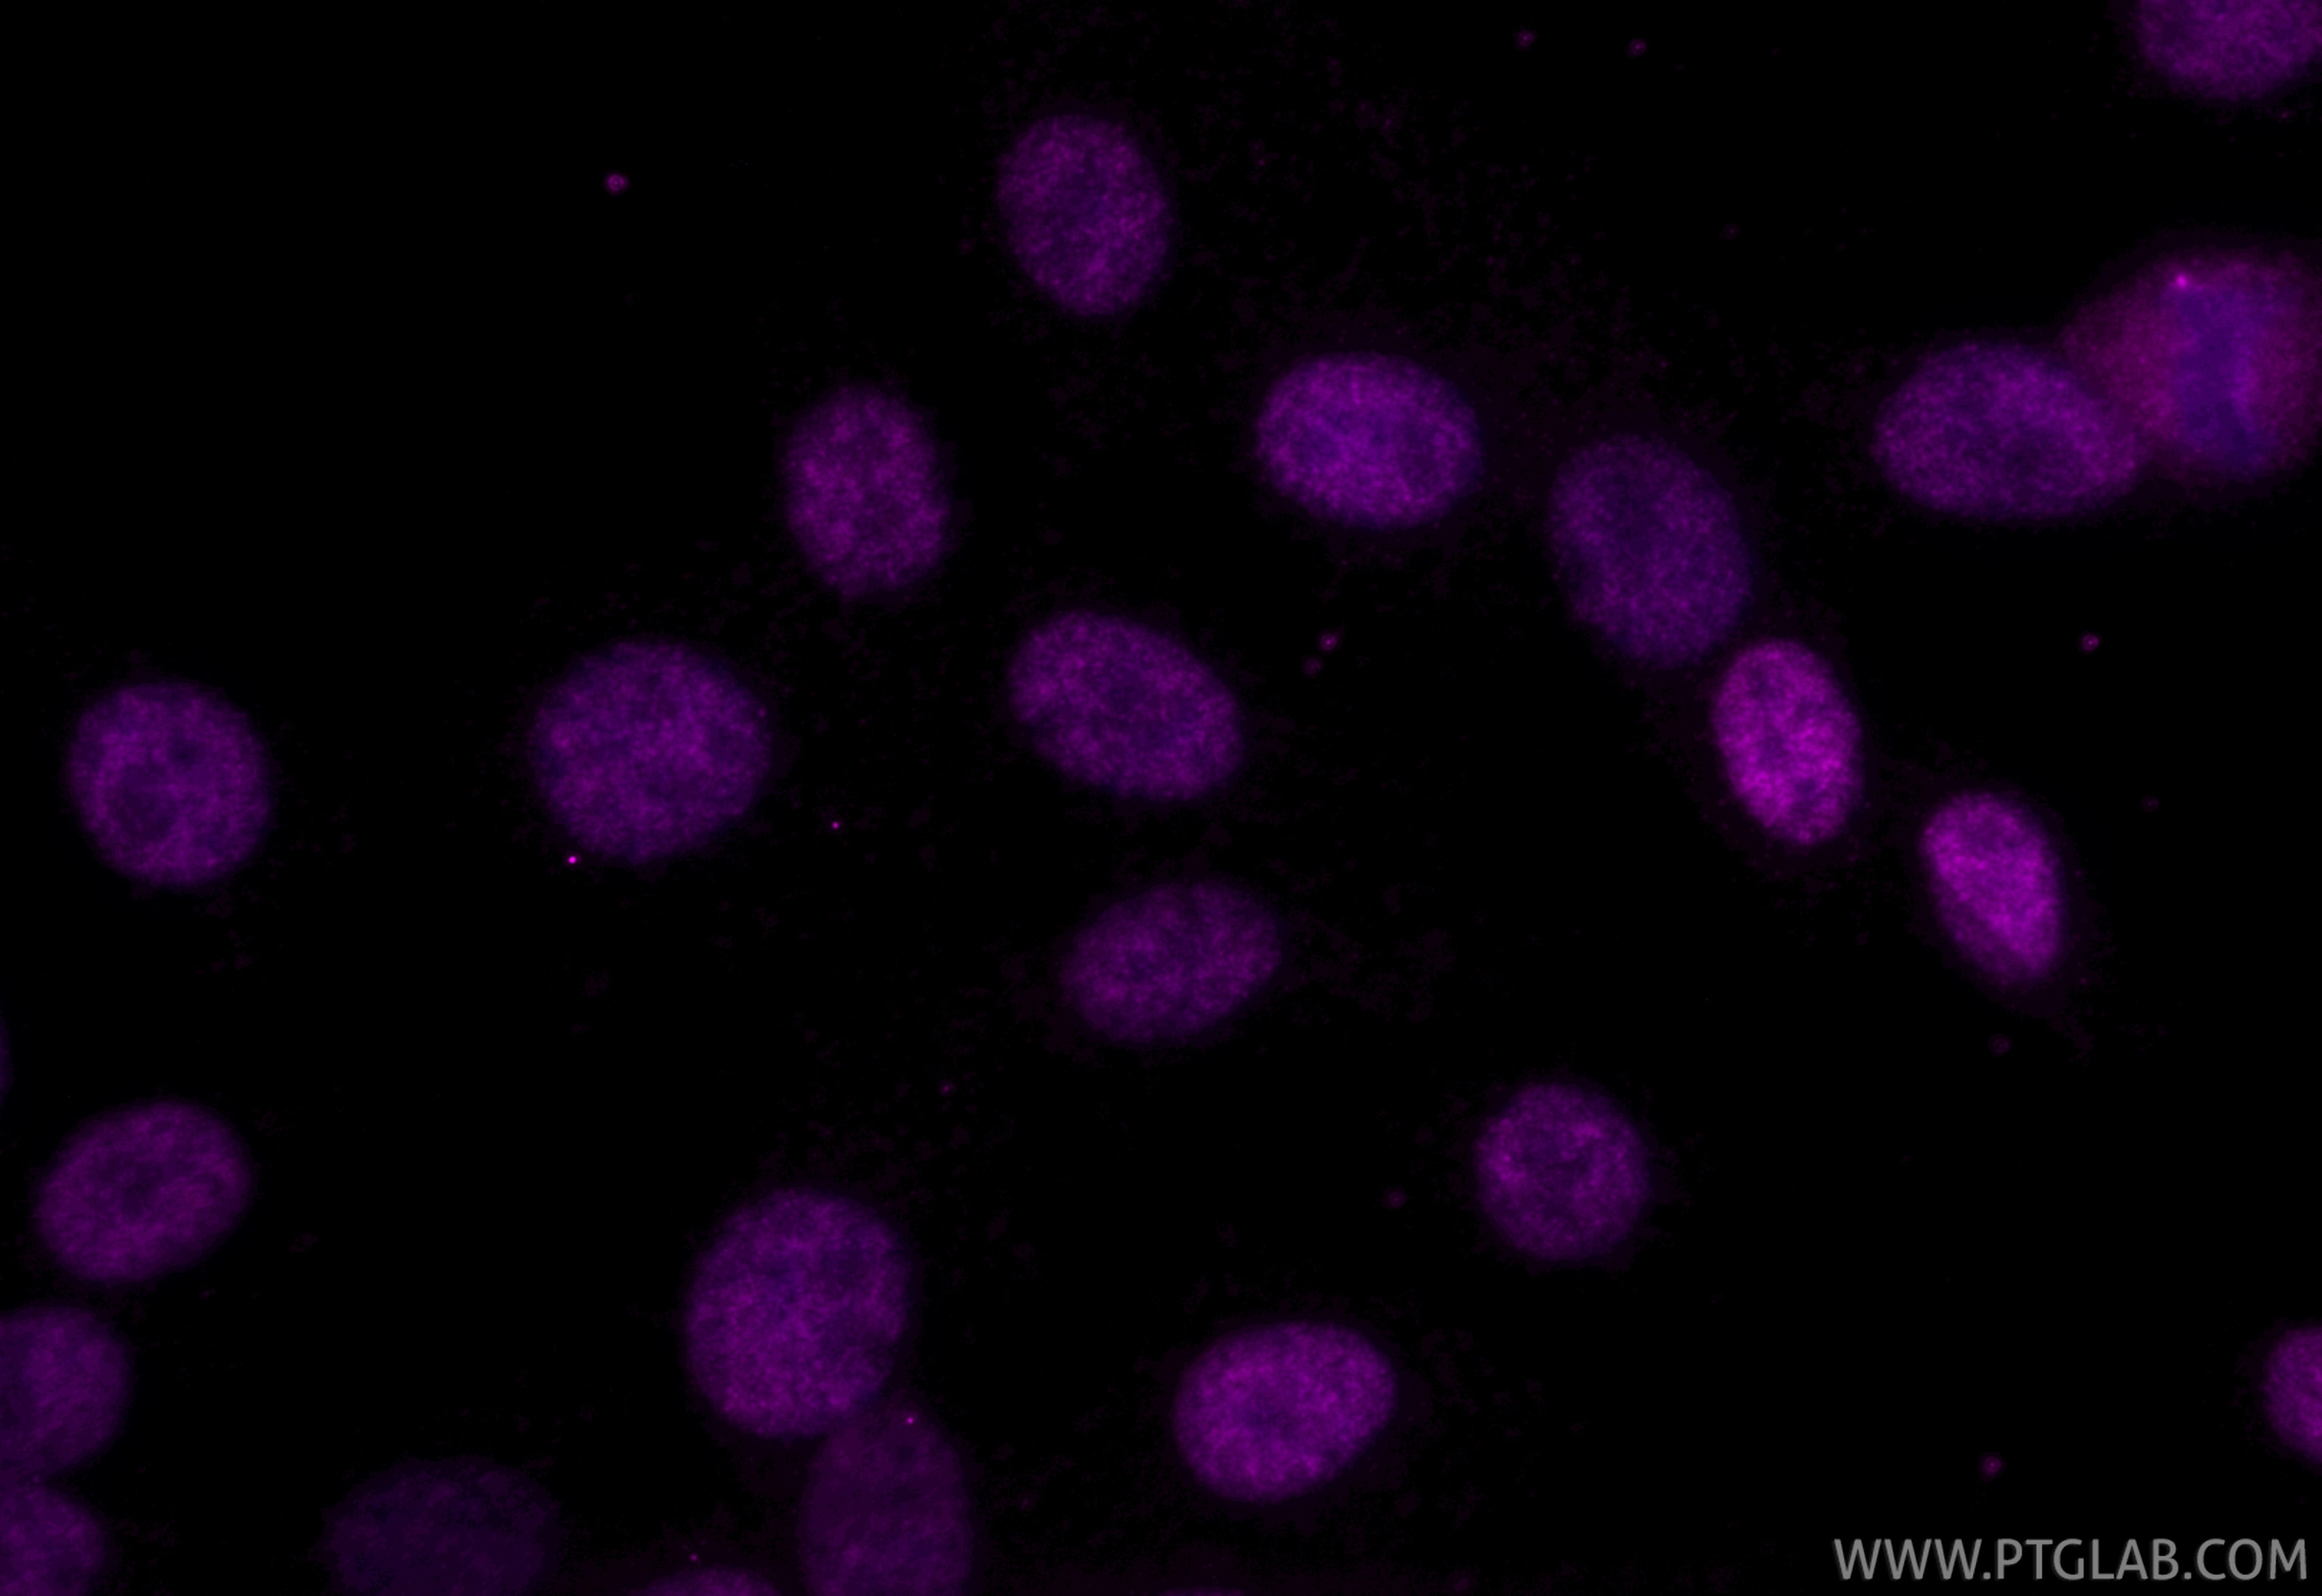
Immunofluorescent analysis of (4% PFA) fixed C6 cells using CoraLite® Plus 647 FOXG1 antibody (CL647-85930, Clone: 250144E8 ) at dilution of 1:200. Immunofluorescence (IF) / fluorescent staining of C6 cells using CoraLite® Plus 647-conjugated FOXG1 Recombinant mo (CL647-85930)

Tested Applications
| Positive IF/ICC detected in | U-251 cells, C6 cells |
| Positive FC (Intra) detected in | U251 |
Recommended dilution
| Application | Dilution |
|---|---|
| Immunofluorescence (IF)/ICC | IF/ICC : 1:50-1:500 |
| Flow Cytometry (FC) (INTRA) | FC (INTRA) : 0.4 ug per 10^6 cells in a 100 µl suspension |
| It is recommended that this reagent should be titrated in each testing system to obtain optimal results. | |
| Sample-dependent, Check data in validation data gallery. | |
Product Information
CL647-85930 targets FOXG1 in IF/ICC, FC (Intra) applications and shows reactivity with human, mouse, rat samples.
| Tested Reactivity | human, mouse, rat |
| Host / Isotype | Rabbit / IgG |
| Class | Recombinant |
| Type | Antibody |
| Immunogen |
CatNo: Ag17169 Product name: Recombinant human FOXG1 protein Source: e coli.-derived, PET28a Tag: 6*His Domain: 190-489 aa of BC035020 Sequence: IMMAIRQSPEKRLTLNGIYEFIMKNFPYYRENKQGWQNSIRHNLSLNKCFVKVPRHYDDPGKGNYWMLDPSSDDVFIGGTTGKLRRRSTTSRAKLAFKRGARLTSTGLTFMDRAGSLYWPMSPFLSLHHPRASSTLSYNGTTSAYPSHPMPYSSVLTQNSLGNNHSFSTANGLSVDRLVNGEIPYATHHLTAAALAASVPCGLSVPCSGTYSLNPCSVNLLAGQTSYFFPHVPHPSMTSQSSTSMSARAASSSTSPQAPSTLPCESLRPSLPSFTTGLSGGLSDYFTHQNQGSSSNPLIH Predict reactive species |
| Full Name | forkhead box G1 |
| Calculated Molecular Weight | 489 aa, 52 kDa |
| Observed Molecular Weight | 60 kDa |
| GenBank Accession Number | BC035020 |
| Gene Symbol | FOXG1 |
| Gene ID (NCBI) | 2290 |
| Conjugate | CoraLite® Plus 647 Fluorescent Dye |
| Excitation/Emission Maxima Wavelengths | 654 nm / 674 nm |
| Excitation Laser | Red Laser (633 nm) |
| Form | Liquid |
| Purification Method | Protein A purification |
| UNIPROT ID | P55316 |
| Storage Buffer | PBS with 50% glycerol, 0.05% Proclin300, 0.5% BSA, pH 7.3. |
| Storage Conditions | Store at -20°C. Avoid exposure to light. Stable for one year after shipment. Aliquoting is unnecessary for -20oC storage. |
Background Information
Forkhead Box G1 (FOXG1) is a member of the Forkhead family of genes with non-redundant roles in brain development, where alteration of this gene's expression significantly affects the formation and function of the mammalian cerebral cortex. FOXG1 haploinsufficiency in humans is associated with prominent differences in brain size and impaired intellectual development noticeable in early childhood, while homozygous mutations are typically fatal.
Protocols
| Product Specific Protocols | |
|---|---|
| FC protocol for CL Plus 647 FOXG1 antibody CL647-85930 | Download protocol |
| IF protocol for CL Plus 647 FOXG1 antibody CL647-85930 | Download protocol |
| Standard Protocols | |
|---|---|
| Click here to view our Standard Protocols |